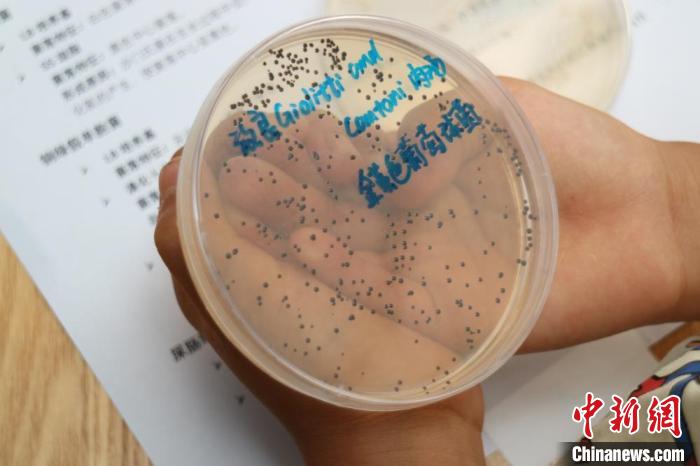

六一儿童节的这一天,山东大学微生物技术国家重点实验室,没有给孩子们安排放假,而是送去了一份格外特别的礼物,这份礼物是让孩子们亲自去接触触摸那个,平常藏在课本当中的微观世界,当“科学”这个词汇,不再仅仅只是试卷上面的考点,而是转变为能够去观察、品尝、操作的实际现实体验,孩子们眼神里面所闪烁的,是比任何玩具都更为持久的光芒。
当实验室变成游乐场
在六月一日上午九点的时候,处于青岛的山东大学微生物技术国家重点实验室的门口,已然排起了长长的队伍,和平时不一样,今日在这儿并没有穿着白大褂的研究员匆忙地进出,而是换成了牵着父母手的那些孩子们,他们发出的笑声使得这座庄重严肃的科研殿堂刹那间转变成了欢乐的海洋。
实验室那批工作人员特意处置了那些平常得严格依照无菌操作要求的实验台,使之转变成为适配孩子们的科普摊位。有把显微镜调节到了最利于小孩子们进行观察的高度,还把培养皿之中装有细菌的部分染出了鲜明艳丽的色彩,甚至就连那些读起来费劲的专业术语,也都被翻转为孩子们能够听得明白的“细菌王国语言”。
舌尖上的酶
有个实验区叫“舌尖上的酶”,在那儿,孩子们正品尝一种特种馒头。研究员告知围一圈的小观众,这些馒头里加了不同的酶,有的能让馒头更甜,有的能使之更软。一个小男孩舔舔嘴唇发问:“酶究竟是好人还是坏人?”此问题令周围家长一阵哄笑。
研究员极具耐心地作出解释,酶自身不存在好坏的分别,如同置于厨房里的刀具,它能夠被用来切菜,也能够被用以伤人,关键之处在于如何去进行使用。借助这般的体验,小孩们不但记住了酶的存有,更为关键的是开始领会科学的中立特性以及人类运用科学的能力。
草莓基因的密室大逃脱
“草莓基因的密室大逃脱”,它是当天最为火爆的那些项目当中的一个。孩子们亲手去从草莓里头提取出DNA,看着那一些肉眼根本就看不见的遗传物质,在试管当中聚集成白色絮状物,好多孩子发出了惊呼。有一位从市南区专门赶过来的家长讲,自己高中的时候才接触到这些知识,现今孩子小学阶段就能亲手进行操作,这样的差距使他感到感慨。
研二学生小张负责这个项目,他说,在设计这个实验时,团队特意选择了草莓而非其他水果,原因是草莓的DNA更易于提取,看到孩子们专注的眼神,他感觉连续准备两周的辛劳都值得了。
一滴水里的动物园
备受欢迎的要数“微观世界真奇妙:一滴水里的动物园” ,孩子们依次趴在显微镜前 ,去瞧一滴池塘水里游动着的草履虫 ,还有旋转着的轮虫。一个扎着马尾的小女孩长时间盯着屏幕 ,忽地抬头问妈妈:“原来我们所饮用的水里有着这般多的动物 ,它们会咬我不?”。
这场景里的这个问题,使得身处现场的那些志愿者全都笑了起来,解说员趁着这个时机,朝着孩子们阐明了自来水厂的净化流程,还告知他们我们所饮用的水为何是安全的方面,而后,源自一滴水起始,直至一个城市的供水体系,这般科学的种子就在不经意之间被种下了。
科学家精神的传承
几道中学生模样的少年,被几张泛黄的手稿以及旧照片吸引住了,这些在科学家精神教育基地中。讲解员跟他们讲述那是山东大学微生物学科奠基人王祖农先生留学归国时所带回的资料。在科研条件艰苦的那个年代,老一辈科学家正是借助这些资料,逐步地构建起中国的微生物研究体系。
这位带着孩子前来参观的父亲,站在展板跟前,看了好长一段时间,他告知孩子,自己在大学念书的时候,所学的专业是生物,虽说当下从事的工作,跟专业并不相干。然而那段在校学习的经历,培育出的科学思维,让他一辈子都受用无穷。这样一种跨越了时间与空间的共鸣,恰恰就是科普活动当中,最为打动人的那一部分内容。
科学种子的意义
活动告终之际,叫做王亚的党政办公室副主任瞧着徐徐散去之人流讲道,挑在儿童节搞开放日,便是要把科学知识当作礼物赠给孩子。这份礼物不会当下就见成效,或许待几年乃至十几年以后,现今某个孩子因这次经历而对科学萌生兴致,最终踏上科研之路,那便是活动最为巨大的成功。
具统计而言,当日存有超过800名市民投身于活动之中,当中近乎半数为少年儿童。实验室所筹备的2000份科普手册于活动起始两小时之内便被领取殆尽,如此这般的热情致使组织者既觉意外又感欣慰。
你可还记着自身头一回接触科学是在啥时候,是哪一个瞬间致使你对这一世界萌生了好奇之情?诚挚地欢迎于评论区去分享你的经历,倘若点赞就能使得更多众看到科学教育所具备的意义。